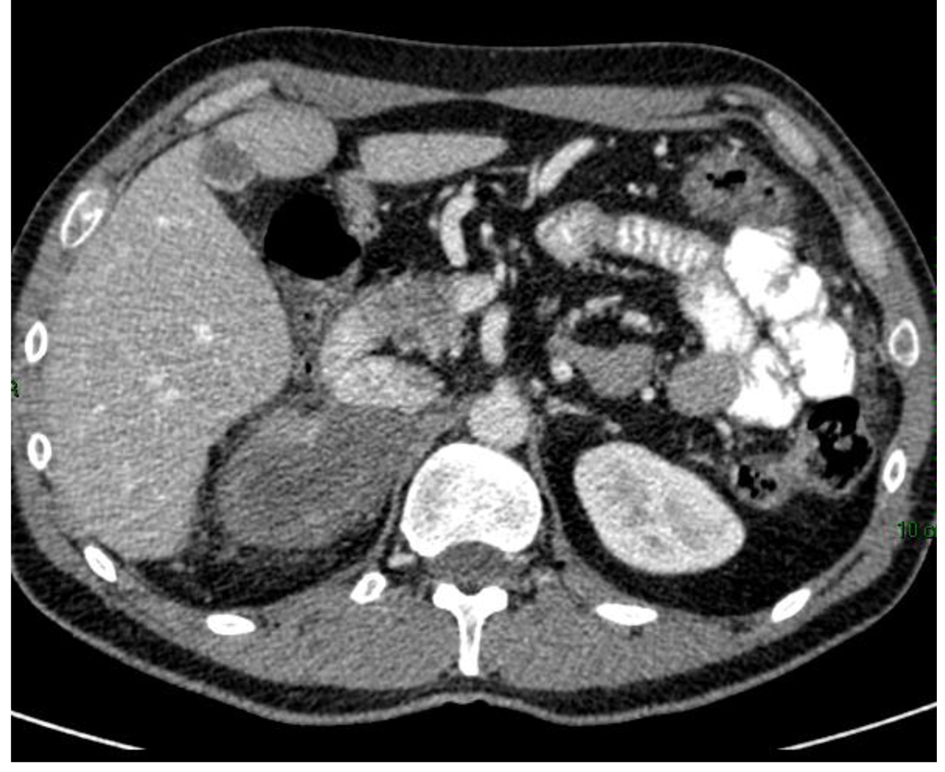
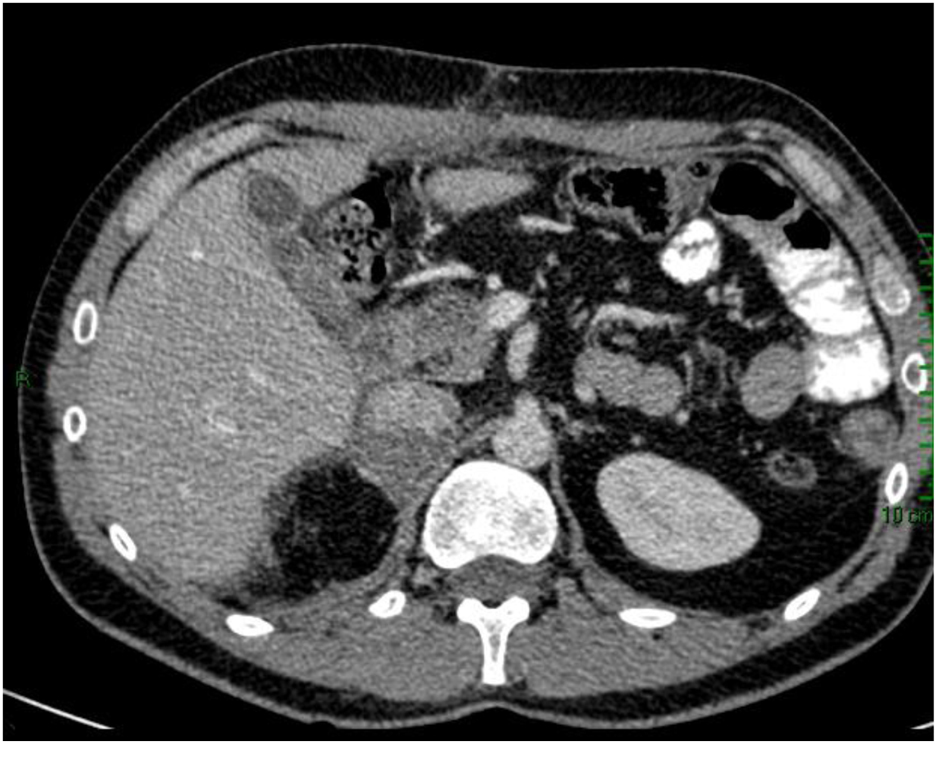

| World Journal of Oncology, ISSN 1920-4531 print, 1920-454X online, Open Access |
| Article copyright, the authors; Journal compilation copyright, World J Oncol and Elmer Press Inc |
| Journal website http://www.wjon.org |
Case Report
Volume 6, Number 6, December 2015, pages 485-490
Clinical Case of Metastatic Adrenocortical Carcinoma With Unusual Evolution: Review the Literature
Luis Cabezon-Gutierreza, c, Ana Isabel Franco-Morenob, Parham Khosravi-Shahia, Sara Custodio-Cabelloa, Maria Jose Garcia-Navarrob, Rosa Maria Martin-Diazb
aDepartment of Medical Oncology, Torrejon University Hospital, Madrid, Spain
bDepartment of Internal Medicine, Torrejon University Hospital, Madrid, Spain
cCorresponding Author: Luis Cabezon-Gutierrez, Department of Medical Oncology, Hospital Universitario de Torrejon, C/Mateo Inurria s/n, CP 28850, Torrejon de Ardoz, Madrid, Spain
Manuscript accepted for publication July 22, 2015
Short title: Metastatic Adrenocortical Carcinoma
doi: http://dx.doi.org/10.14740/wjon936w
| Abstract | ▴Top |
Adrenocortical carcinoma (ACC) is a rare and heterogeneous malignancy, with an incidence of approximately 0.72 per million cases per year leading to 0.2% of all cancer deaths in the United States. Metastatic ACC has a dismal prognosis with an overall survival of less than 1 year. We present a case of a 37-year-old man with metastatic ACC with unusual good prognosis and review the therapeutic options in the literature.
Keywords: Adrenocortical carcinoma; Mitotane; Chemotherapy
| Introduction | ▴Top |
Adrenocortical carcinoma (ACC) is a rare and heterogeneous malignancy. Adrenal tumors are very common, affecting 3-10% of the human population, and the majority are small benign non-functional adrenocortical adenomas [1]. ACC, in contrast, is a very rare disease. The Surveillance, Epidemiology, and End Results (SEER) database provides an estimation of incidence of approximately 0.72 per million cases per year leading to 0.2% of all cancer deaths in the United States [2]. The median age at diagnosis is 46 - 55 years [3]. Historically only about 30% of these malignancies are confined to the adrenal gland at the time of diagnosis. In these cases, an open resection performed by a specialized surgeon to achieve a state of no residual disease offers the best chance for cure [2]. Reoperation in case of a recurrence has been suggested to improve survival, but those studies are retrospective and may suffer from a selection bias with inclusion of patients with more indolent clinical presentations [4, 5].
Metastatic ACC has a dismal prognosis with an overall survival of less than 1 year [6]. The most common sites of metastases are the lung, liver, lymph nodes, and less commonly, the bones [2]. Palliation of functioning tumors may be achieved by resection of both the primary tumor and metastatic lesions. Unresectable or widely disseminated tumors may be palliated by adrenolytic therapy with mitotane and other antihormonal drugs (i.e., ketoconazole), and less frequently by systemic chemotherapy, and/or radiation therapy [7]. However, 5-year survival for patients with stage IV tumors is less than 20% [8, 9]. In the present communication, we describe a case in adult metastatic ACC with unusual good evolution.
| Case Report | ▴Top |
A 37-year-old man with no past medical history of hypertension or prior malignancy was admitted to the University Hospitals of Torrejon (Madrid, Spain) in July 2013 with worsening epigastric pain, decreased appetite, and 10 kg loss of weight over 6 months. His abdomen was mildly distended and on physical examination presented ascites. Computerized tomography (CT) (Fig. 1) revealed a huge heterogeneous adrenal tumor (13 cm in diameter) on the right side, compressing the inferior vena cava (IVC) and peritoneal carcinomatosis.
![]() Click for large image | Figure 1. CT scan of adrenocortical carcinoma showing necrotic right adrenal mass in close proximity to the body/tail of pancreas and third portion of the duodenum (white arrow). |
The laboratory studies did not show significant steroid hormone or catecholamine excess. A biopsy was then obtained from the adrenal mass. The tumor showed necrosis. The epithelioid component consisted of sheet and nests of loosely cohesive polygonal cells with clear and eosinophilic cytoplasm resembling adrenocortical cells. These cells showed highly atypical nuclei and large eosinophilic nucleoli. Immunohistochemical stains for AE1/AE3, S-100, calcitonin, ACTH, and chromogranin were negative. The Ki-67 proliferation index was 10%.
The patient was subsequently started on the EDP-mitotane regimen consisting of etoposide at a dose of 100 mg/m2 of body surface area administered intravenously on days 2, 3, and 4 of each cycle; doxorubicin at a dose of 40 mg/m2 given intravenously on day 1; cisplatin at a dose of 40 mg/m2 given intravenously on days 3 and 4; and oral mitotane administered continuously. One cycle of the regimen was defined as a 4-week interval. The patient received a total of six cycles of chemotherapy. Mitotane was started a minimum of 1 week before the initiation of the cytotoxic treatment, with the goal of attaining a blood level of 14 - 20 mg/L. Glucocorticoid replacement therapy was performed from the beginning of treatment with mitotane.
Six months after administration of mitotane, CT scan showed a reduction in size of the adrenal mass and the peritoneal metastases (Fig. 2), with a total reduction (RECIST criteria) around 40%.
![]() Click for large image | Figure 2. CT scan 6 months after mitotane treatment showing reduction in size of the adrenal mass. |
Subsequently, the patient was taken to the surgical oncology and had right radical adrenelectomy and total omentectomy. The final pathology report showed adrenocortical carcinoma, reaching surgical margins; vascular invasion; histological changes consistent with minor changes to neoadjuvant therapy; round stent without significant histological alterations; and YpT3NxM1 pathological staging. Post-surgical CT scan showed complete omentectomy and right adrenalectomy. However, an adrenal tissue around 7 × 3 cm which impresses tumor was observed. Visceral, peritoneal or bone metastatic lesions are discarded (Fig. 3).
![]() Click for large image | Figure 3. CT scan after surgical oncology showing right radical adrenalectomy and total omentectomy. |
After the operation, the patient continues treatment with mitotane, requiring frequent adjustments in dosage to maintain serum levels between 14 and 20 mg/L, and is still alive without progression 2 years after diagnosis.
| Discussion | ▴Top |
ACC management often requires a multidisciplinary approach, frequently involving a medical oncologist, an endocrine surgeon, an endocrinologist and several other disciplines. Surgical resection remains the corner-stone of the treatment and represents the only curative option for patients with early stage ACC. However, around 80% of these patients will present local or distant recurrence after a complete resection [10]. With regard to recurrent or advanced disease, ACC is modestly responsive to standard cytotoxic chemotherapies, although various combinations have shown clear palliative benefit. Radiation and ablative techniques have been utilized with variable benefit depending on the clinical scenario. The pipeline for novel drug development and testing in clinical trials has been limited. The most frequently used systemic drugs in the advanced disease include mitotane, cisplatin and etoposide used alone or in combination with other agents [11].
Even if the tumor cannot be removed entirely, some clinicians advocate maximal debulking as a means of improving survival [12-14], although others disagree as to the survival benefit of this strategy [15, 16]. Data to support routine debulking of non-resectable tumors are lacking and decision making must be individualized, taking into account the underlying tumor biology, rate of progression, and the histologic grade [17].
Several studies confirm the prognostic value of markers of proliferation, including mitotic rate, and Ki-67 expression (as detected by a monoclonal antibody against Ki-67, MIB1) [18, 19]. The importance of proliferative rate in prognostication was shown in an analysis of 124 patients with ACC, in whom the 5-year disease-specific survival rates for individuals with tumor mitotic rates of ≤ 5, 6 - 10, 21 - 50, and > 50 per 50 high-power fields were 63%, 50%, 25%, and 0%, respectively [18]. Malandrino et al demonstrated in the multivariate analysis like mitotane level 14 mg/L and objective response to platinum-based chemotherapy were found to be independent predictors of survival (P < 0.03 and P < 0.001). This study suggests a prognostic role for mitotane therapy and objective response to platinum-based chemotherapy [20].
Evidence for use of mitotane as the only approved drug for advanced ACC is based on retrospective series of data as opposed to any prospective, randomized controlled trials. Mitotane is considered one of the most active agents in ACC with response rates ranging from 13% to 31% [21]. However, complete responses rarely occur. In terms of overall survival, four studies concluded that mitotane treatment does not increase the survival rate whereas five found an increase in the survival rate [13, 21-23].
Primary treatment with mitotane may be indicated for patients who have histologically proven ACC in whom surgery is incomplete, not feasible, or contraindicated. The quality of the available literature on mitotane monotherapy is poor, and the results are highly variable. Most studies were conducted in early years without monitoring of tumor response with adequate imaging. It is generally accepted, though not proven, that chemotherapy plus mitotane produces better outcomes than does mitotane alone. Therefore, in the setting of extensive (multiple tumor-involved organs) rapidly progressive high-grade disease, mitotane is almost always administered in combination with cytotoxic chemotherapy. A few prospective trials have explored combination regimens that contain mitotane (Table 1) [24-27].
![]() Click to view | Table 1. Cytotoxic Chemotherapy Plus Mitotane in ACC [24-27] |
Although no chemotherapy regimen has been shown to improve overall survival in patients with advanced ACC, some of the more encouraging results have been with the combination of EDP plus mitotane. The largest trial of advanced ACC to date, the First International Randomized trial in locally advanced and Metastatic Adrenocortical Carcinoma Treatment (FIRM-ACT), randomly assigned 304 patients with advanced ACC not amenable to radical surgery to mitotane plus either EDP or streptozotocin [27]. Rates of objective tumor response (23% versus 9%) and median progression-free survival (PFS) (5 versus 2.1 months) were both significantly better in the EDP-mitotane (EDP-M) group, although these benefits did not translate into a significantly prolonged survival (median 14.8 versus 12 months). This lack of significant difference in overall survival, despite better PFS for EDP-M, is possibly due to the cross-over design of the study, since EDP-M was superior as a second-line treatment as well. Rates of serious adverse events did not differ significantly between treatments. The efficacy of both regimens as second-line therapy was similar to their efficacy as first-line therapy. Results with other chemotherapy drugs combined with mitotane seem to be less promising [26-29].
Because of the age of our patient, low Ki-67 (< 10%), good response to chemotherapy and good performance status (0), we decided to perform debulking surgery and subsequently maintaining mitotane therapy. From the date of diagnosis of the disease, it has not been objectified progression, with a PFS of 24 months, which exceeds the usual median of 5 months [27]. This difference is probably explained by the patient’s age, good performance status, Ki-67 < 10% and the possibility of debulking surgery.
A better understanding of ACC biology has provided some rationale for the development of novel agents in this disease. Unfortunately, new agents have resulted in minimal or no activity and new investigations/clinical trials need to be encouraged to incorporate this strategy in the clinical practice (Table 2) [30-41].
![]() Click to view | Table 2. Cytotoxic Chemotherapy in ACC [31-41] |
A placebo-controlled phase III trial of linsitinib, an oral small molecule of both the IGF-1R and insulin receptor, in advanced ACC failed to demonstrate any benefit in disease-free or overall survival [31]. However, as with cixutumumab, partial responses and disease stabilization (in some cases lasting for years) were seen in a small subset of patients. Although IGF-1R inhibitors cannot yet be recommended to any patient with advanced ACC, ongoing efforts to determine the genetic fingerprint that defines it will hopefully allow future selection of patients who might benefit from this approach.
The role of immune regulation in tumor progression and metastasis has been investigated and the interest in this subject is tremendously increasing. As an example, blocking programmed death-1 (PD-1), an inhibitory receptor expressed on activated T cells, results in significant antitumor activity in several malignancies. Efforts should be also done to clarify the potential of novel immunotherapies to treat ACC and at least to interrogate the expression of the PD-1 ligand on tumor cells [30].
Conclusion
The outcomes of the patient reported here with survival greater than 24 months argue for an aggressive treatment approach using a multidisciplinary team to discuss treatment options including chemotherapy, surgery and mitotane when feasible.
Conflict of Interest
The authors declare no conflict of interest.
| References | ▴Top |
- Mansmann G, Lau J, Balk E, Rothberg M, Miyachi Y, Bornstein SR. The clinically inapparent adrenal mass: update in diagnosis and management. Endocr Rev. 2004;25(2):309-340.
doi pubmed - Kebebew E, Reiff E, Duh QY, Clark OH, McMillan A. Extent of disease at presentation and outcome for adrenocortical carcinoma: have we made progress? World J Surg. 2006;30(5):872-878.
doi pubmed - Bilimoria KY, Shen WT, Elaraj D, Bentrem DJ, Winchester DJ, Kebebew E, Sturgeon C. Adrenocortical carcinoma in the United States: treatment utilization and prognostic factors. Cancer. 2008;113(11):3130-3136.
doi pubmed - Fassnacht M, Kroiss M, Allolio B. Update in adrenocortical carcinoma. J Clin Endocrinol Metab. 2013;98(12):4551-4564.
- Erdogan I, Deutschbein T, Jurowich C, Kroiss M, Ronchi C, Quinkler M, Waldmann J, et al. The role of surgery in the management of recurrent adrenocortical carcinoma. J Clin Endocrinol Metab. 2013;98(1):181-191.
doi pubmed - Kerkhofs TM, Verhoeven RH, Van der Zwan JM, Dieleman J, Kerstens MN, Links TP, Van de Poll-Franse LV, et al. Adrenocortical carcinoma: a population-based study on incidence and survival in the Netherlands since 1993. Eur J Cancer. 2013;49(11):2579-2586.
doi pubmed - Burotto M, Tageja N, Rosenberg A, Mahalingam S, Quezado M, Velarde M, Edgerly M, et al. Brain metastasis in patients with adrenocortical carcinoma: a clinical series. J Clin Endocrinol Metab. 2015;100(2):331-336.
doi pubmed - Giordano TJ, Kuick R, Else T, Gauger PG, Vinco M, Bauersfeld J, Sanders D, et al. Molecular classification and prognostication of adrenocortical tumors by transcriptome profiling. Clin Cancer Res. 2009;15(2):668-676.
doi pubmed - Assie G, Letouze E, Fassnacht M, Jouinot A, Luscap W, Barreau O, Omeiri H, et al. Integrated genomic characterization of adrenocortical carcinoma. Nat Genet. 2014;46(6):607-612.
doi pubmed - Dackiw AP, Lee JE, Gagel RF, Evans DB. Adrenal cortical carcinoma. World J Surg. 2001;25(7):914-926.
doi pubmed - Abraham J, Bakke S, Rutt A, Meadows B, Merino M, Alexander R, Schrump D, et al. A phase II trial of combination chemotherapy and surgical resection for the treatment of metastatic adrenocortical carcinoma: continuous infusion doxorubicin, vincristine, and etoposide with daily mitotane as a P-glycoprotein antagonist. Cancer. 2002;94(9):2333-2343.
doi pubmed - Bertagna C, Orth DN. Clinical and laboratory findings and results of therapy in 58 patients with adrenocortical tumors admitted to a single medical center (1951 to 1978). Am J Med. 1981;71(5):855-875.
doi - Luton JP, Cerdas S, Billaud L, Thomas G, Guilhaume B, Bertagna X, Laudat MH, et al. Clinical features of adrenocortical carcinoma, prognostic factors, and the effect of mitotane therapy. N Engl J Med. 1990;322(17):1195-1201.
doi pubmed - Grondal S, Cedermark B, Eriksson B, Grimelius L, Harach R, Kristoffersson A, Rastad J, et al. Adrenocortical carcinoma. A retrospective study of a rare tumor with a poor prognosis. Eur J Surg Oncol. 1990;16(6):500-506.
pubmed - Hogan TF, Gilchrist KW, Westring DW, Citrin DL. A clinical and pathological study of adrenocortical carcinoma: therapeutic implications. Cancer. 1980;45(11):2880-2883.
doi - Wajchenberg BL, Albergaria Pereira MA, Medonca BB, Latronico AC, Campos Carneiro P, Alves VA, Zerbini MC, et al. Adrenocortical carcinoma: clinical and laboratory observations. Cancer. 2000;88(4):711-736.
doi - Schteingart DE, Doherty GM, Gauger PG, Giordano TJ, Hammer GD, Korobkin M, Worden FP. Management of patients with adrenal cancer: recommendations of an international consensus conference. Endocr Relat Cancer. 2005;12(3):667-680.
doi pubmed - Stojadinovic A, Ghossein RA, Hoos A, Nissan A, Marshall D, Dudas M, Cordon-Cardo C, et al. Adrenocortical carcinoma: clinical, morphologic, and molecular characterization. J Clin Oncol. 2002;20(4):941-950.
doi pubmed - Assie G, Antoni G, Tissier F, Caillou B, Abiven G, Gicquel C, Leboulleux S, et al. Prognostic parameters of metastatic adrenocortical carcinoma. J Clin Endocrinol Metab. 2007;92(1):148-154.
doi pubmed - Malandrino P, Al Ghuzlan A, Castaing M, Young J, Caillou B, Travagli JP, Elias D, et al. Prognostic markers of survival after combined mitotane- and platinum-based chemotherapy in metastatic adrenocortical carcinoma. Endocr Relat Cancer. 2010;17(3):797-807.
doi pubmed - Haak HR, Hermans J, van de Velde CJ, Lentjes EG, Goslings BM, Fleuren GJ, Krans HM. Optimal treatment of adrenocortical carcinoma with mitotane: results in a consecutive series of 96 patients. Br J Cancer. 1994;69(5):947-951.
doi pubmed - Heilmann P, Wagner P, Nawroth PP, Ziegler R. [Therapy of the adrenocortical carcinoma with Lysodren (o,p'-DDD). Therapeutic management by monitoring o,p'-DDD blood levels]. Med Klin (Munich). 2001;96(7):371-377.
doi - Pommier RF, Brennan MF. An eleven-year experience with adrenocortical carcinoma. Surgery. 1992;112(6):963-970; discussion 970-961.
- Williamson SK, Lew D, Miller GJ, Balcerzak SP, Baker LH, Crawford ED. Phase II evaluation of cisplatin and etoposide followed by mitotane at disease progression in patients with locally advanced or metastatic adrenocortical carcinoma: a Southwest Oncology Group Study. Cancer. 2000;88(5):1159-1165.
doi - Berruti A, Terzolo M, Pia A, Angeli A, Dogliotti L. Mitotane associated with etoposide, doxorubicin, and cisplatin in the treatment of advanced adrenocortical carcinoma. Italian Group for the Study of Adrenal Cancer. Cancer. 1998;83(10):2194-2200.
doi - Khan TS, Imam H, Juhlin C, Skogseid B, Grondal S, Tibblin S, Wilander E, et al. Streptozocin and o,p'DDD in the treatment of adrenocortical cancer patients: long-term survival in its adjuvant use. Ann Oncol. 2000;11(10):1281-1287.
doi pubmed - Fassnacht M, Terzolo M, Allolio B, Baudin E, Haak H, Berruti A, Welin S, et al. Combination chemotherapy in advanced adrenocortical carcinoma. N Engl J Med. 2012;366(23):2189-2197.
doi pubmed - Sperone P, Ferrero A, Daffara F, Priola A, Zaggia B, Volante M, Santini D, et al. Gemcitabine plus metronomic 5-fluorouracil or capecitabine as a second-/third-line chemotherapy in advanced adrenocortical carcinoma: a multicenter phase II study. Endocr Relat Cancer. 2010;17(2):445-453.
doi pubmed - Redlich A, Boxberger N, Strugala D, Fruhwald MC, Leuschner I, Kropf S, Bucsky P, et al. Systemic treatment of adrenocortical carcinoma in children: data from the German GPOH-MET 97 trial. Klin Padiatr. 2012;224(6):366-371.
doi pubmed - Fay AP, Elfiky A, Telo GH, McKay RR, Kaymakcalan M, Nguyen PL, Vaidya A, et al. Adrenocortical carcinoma: the management of metastatic disease. Crit Rev Oncol Hematol. 2014;92(2):123-132.
doi pubmed - Fassnacht M, Berruti A, Baudin E, Demeure MJ, Gilbert J, Haak H, Kroiss M, et al. Linsitinib (OSI-906) versus placebo for patients with locally advanced or metastatic adrenocortical carcinoma: a double-blind, randomised, phase 3 study. Lancet Oncol. 2015;16(4):426-435.
doi - Kroiss M, Quinkler M, Johanssen S, van Erp NP, Lankheet N, Pollinger A, Laubner K, et al. Sunitinib in refractory adrenocortical carcinoma: a phase II, single-arm, open-label trial. J Clin Endocrinol Metab. 2012;97(10):3495-3503.
doi pubmed - Berruti A, Sperone P, Ferrero A, Germano A, Ardito A, Priola AM, De Francia S, et al. Phase II study of weekly paclitaxel and sorafenib as second/third-line therapy in patients with adrenocortical carcinoma. Eur J Endocrinol. 2012;166(3):451-458.
doi pubmed - Wortmann S, Quinkler M, Ritter C, Kroiss M, Johanssen S, Hahner S, Allolio B, et al. Bevacizumab plus capecitabine as a salvage therapy in advanced adrenocortical carcinoma. Eur J Endocrinol. 2010;162(2):349-356.
doi pubmed - Quinkler M, Hahner S, Wortmann S, Johanssen S, Adam P, Ritter C, Strasburger C, et al. Treatment of advanced adrenocortical carcinoma with erlotinib plus gemcitabine. J Clin Endocrinol Metab. 2008;93(6):2057-2062.
doi pubmed - Samnotra V, Vassilopoulou-Sellin R, Fojo AT, et al. A phase II trial of gefitinib monotherapy in patients with unresectable adrenocortical carcinoma (ACC). In: Annual meeting proceedings (post-meeting edition),25. 2007 [Abstr. 15527].
- Haluska P, Worden F, Olmos D, Yin D, Schteingart D, Batzel GN, Paccagnella ML, et al. Safety, tolerability, and pharmacokinetics of the anti-IGF-1R monoclonal antibody figitumumab in patients with refractory adrenocortical carcinoma. Cancer Chemother Pharmacol. 2010;65(4):765-773.
doi pubmed - Carden CP, Kim ES, Jones RL, et al. Phase I study of intermittent dosing of OSI-906, a dual tyrosine kinase inhibitor of insulin-like growthfactor-1 receptor (IGF-1R) and insulin receptor (IR) in patients with advanced solid tumors. J Clin Oncol. 2010;28(Suppl.):15s [abstr 2530].
- Naing A, Kurzrock R, Burger A, Gupta S, Lei X, Busaidy N, Hong D, et al. Phase I trial of cixutumumab combined with temsirolimus in patients with advanced cancer. Clin Cancer Res. 2011;17(18):6052-6060.
doi pubmed - Fraenkel M, Gueorguiev M, Barak D, Salmon A, Grossman AB, Gross DJ. Everolimus therapy for progressive adrenocortical cancer. Endocrine. 2013;44(1):187-192.
doi pubmed - Gross DJ, Munter G, Bitan M, Siegal T, Gabizon A, Weitzen R, Merimsky O, et al. The role of imatinib mesylate (Glivec) for treatment of patients with malignant endocrine tumors positive for c-kit or PDGF-R. Endocr Relat Cancer. 2006;13(2):535-540.
doi pubmed
This is an open-access article distributed under the terms of the Creative Commons Attribution License, which permits unrestricted use, distribution, and reproduction in any medium, provided the original work is properly cited.
World Journal of Oncology is published by Elmer Press Inc.